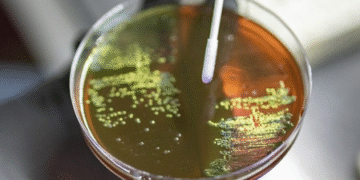
HEALTH & MEDICINE : ਗਰਭ ਅਵਸਥਾ ਦੌਰਾਨ ਐਂਟੀਬਾਇਓਟਿਕ ਦੀ ਵਰਤੋਂ ਬੱਚਿਆਂ ਵਿੱਚ ਵਧਾ ਸਕਦੀ ਹੈ ਬੈਕਟੀਰੀਆ ਸੰਬੰਧੀ ਬਿਮਾਰੀ ਦਾ ਖਤਰਾ

HEALTH & MEDICINE : ਗਰਭ ਅਵਸਥਾ ਦੌਰਾਨ ਐਂਟੀਬਾਇਓਟਿਕ ਦੀ ਵਰਤੋਂ ਬੱਚਿਆਂ ਵਿੱਚ ਵਧਾ ਸਕਦੀ ਹੈ ਬੈਕਟੀਰੀਆ ਸੰਬੰਧੀ ਬਿਮਾਰੀ ਦਾ ਖਤਰਾ

ਨਵੀਂ ਦਿੱਲੀ, 10 ਜਨਵਰੀ (ਵਿਸ਼ਵ ਵਾਰਤਾ) HEALTH & MEDICINE : ਇੱਕ ਅਧਿਐਨ ਦੇ ਅਨੁਸਾਰ ਗਰਭ ਅਵਸਥਾ ਦੌਰਾਨ ਮਾਂ ਦੁਆਰਾ ਐਂਟੀਬਾਇਓਟਿਕਸ ਦੀ ਵਰਤੋਂ ਬੱਚਿਆਂ ਵਿੱਚ ਗਰੁੱਪ ਬੀ ਸਟ੍ਰੈਪਟੋਕਾਕਸ (ਜੀਬੀਐਸ) ਬਿਮਾਰੀ – ਇੱਕ ਆਮ ਬੈਕਟੀਰੀਆ ਸੰਬੰਧੀ ਬਿਮਾਰੀ, ਦੇ ਵਿਕਾਸ ਦੇ ਜੋਖਮ ਨੂੰ ਵਧਾ ਸਕਦੀ ਹੈ।
ਜਦੋਂ ਕਿ ਬੈਕਟੀਰੀਆ ਆਮ ਤੌਰ ‘ਤੇ ਅੰਤੜੀਆਂ ਜਾਂ ਜਣਨ ਟ੍ਰੈਕਟ ਵਿੱਚ ਨੁਕਸਾਨਦੇਹ ਰਹਿੰਦੇ ਹਨ, ਉਹ ਗੰਭੀਰ ਲਾਗਾਂ ਦਾ ਕਾਰਨ ਬਣ ਸਕਦੇ ਹਨ, ਖਾਸ ਕਰਕੇ ਨਵਜੰਮੇ ਬੱਚਿਆਂ, ਬਜ਼ੁਰਗਾਂ ਅਤੇ ਇਮਯੂਨੋਕੰਪਰੋਮਾਈਜ਼ਡ ਵਿਅਕਤੀਆਂ ਵਿੱਚ, ਜਿਸ ਨਾਲ ਸੈਪਸਿਸ, ਮੈਨਿਨਜਾਈਟਿਸ ਅਤੇ ਨਮੂਨੀਆ ਹੋ ਸਕਦਾ ਹੈ।
ਸਵੀਡਨ ਵਿੱਚ ਕੈਰੋਲਿੰਸਕਾ ਇੰਸਟੀਚਿਊਟ, ਬੈਲਜੀਅਮ ਵਿੱਚ ਐਂਟਵਰਪ ਯੂਨੀਵਰਸਿਟੀ ਦੀ ਇੱਕ ਅੰਤਰਰਾਸ਼ਟਰੀ ਟੀਮ ਦੀ ਅਗਵਾਈ ਵਿੱਚ ਕੀਤੇ ਗਏ ਅਧਿਐਨ ਨੇ ਦਿਖਾਇਆ ਕਿ ਜਣੇਪੇ ਦੇ ਚਾਰ ਹਫ਼ਤਿਆਂ ਦੇ ਅੰਦਰ, ਜਣੇਪੇ ਤੋਂ ਪਹਿਲਾਂ ਐਂਟੀਬਾਇਓਟਿਕ ਐਕਸਪੋਜਰ ਨਵਜੰਮੇ ਜੀਬੀਐਸ ਬਿਮਾਰੀ ਦੇ ਵਧੇ ਹੋਏ ਜੋਖਮ ਨਾਲ ਜੁੜਿਆ ਹੋਇਆ ਸੀ। ਸ਼ੁਰੂਆਤੀ ਤੀਜੀ-ਤਿਮਾਹੀ ਦੇ ਐਕਸਪੋਜਰ ਨੇ ਸਭ ਤੋਂ ਮਜ਼ਬੂਤ ਸਬੰਧ ਦਿਖਾਇਆ।

ਖੋਜਕਰਤਾਵਾਂ ਨੇ ਜਰਨਲ ਆਫ਼ ਇਨਫੈਕਸ਼ਨ ਵਿੱਚ ਪੇਪਰ ਵਿੱਚ ਕਿਹਾ “ਪ੍ਰੀਨੇਟਲ ਐਂਟੀਬਾਇਓਟਿਕ ਐਕਸਪੋਜਰ ਚਾਰ ਹਫ਼ਤਿਆਂ ਦੇ ਅੰਦਰ ਜਣੇਪੇ ਤੋਂ ਬਾਅਦ ਜੀਬੀਐਸ ਜੋਖਮ ਨੂੰ ਵਧਾ ਸਕਦਾ ਹੈ, ਖਾਸ ਕਰਕੇ ਨਵਜੰਮੇ ਬੱਚਿਆਂ ਵਿੱਚ ਜੋ ਜੋਖਮ-ਅਧਾਰਤ ਇੰਟਰਾਪਾਰਟਮ ਪ੍ਰੋਫਾਈਲੈਕਸਿਸ ਦੁਆਰਾ ਕਵਰ ਨਹੀਂ ਕੀਤੇ ਜਾਂਦੇ ਹਨ, ਸ਼ੁਰੂਆਤੀ ਤੀਜੀ ਤਿਮਾਹੀ ਸੰਵੇਦਨਸ਼ੀਲਤਾ ਦੀ ਇੱਕ ਮਹੱਤਵਪੂਰਨ ਖਿੜਕੀ ਹੈ,” ।
ਟੀਮ ਨੇ 2006 ਤੋਂ 2016 ਤੱਕ ਸਵੀਡਨ ਵਿੱਚ ਸਾਰੇ ਸਿੰਗਲਟਨ ਲਾਈਵ ਜਨਮਾਂ ਸਮੇਤ ਆਬਾਦੀ-ਅਧਾਰਤ ਸਮੂਹ ਅਧਿਐਨ ਕੀਤਾ, ਜਿਸ ਵਿੱਚ ਰਾਸ਼ਟਰੀ ਰਜਿਸਟਰਾਂ ਦੀ ਵਰਤੋਂ ਕੀਤੀ ਗਈ। 1,095,644 ਲਾਈਵ ਜਨਮੇ ਸਿੰਗਲਟਨ ਬੱਚਿਆਂ ਵਿੱਚੋਂ, 24.5 ਪ੍ਰਤੀਸ਼ਤ ਐਂਟੀਬਾਇਓਟਿਕਸ ਦੇ ਸੰਪਰਕ ਵਿੱਚ ਆਏ ਸਨ।

ਜੀਬੀਐਸ ਦੀਆਂ ਘਟਨਾਵਾਂ ਅਣ-ਐਕਸਪੋਜ਼ਰ ਕੀਤੇ ਗਏ ਨਵਜੰਮੇ ਬੱਚਿਆਂ ਵਿੱਚ (0.86 ਬਨਾਮ 0.66 ਪ੍ਰਤੀ 1,000 ਲਾਈਵ ਜਨਮਾਂ ਵਿੱਚ) ਵੱਧ ਪਾਈਆਂ ਗਈਆਂ, ਖਾਸ ਕਰਕੇ ਜੀਬੀਐਸ ਜੋਖਮ ਕਾਰਕਾਂ ਤੋਂ ਬਿਨਾਂ ਨਵਜੰਮੇ ਬੱਚਿਆਂ ਵਿੱਚ।
ਖੋਜਕਰਤਾਵਾਂ ਦੇ ਅਨੁਸਾਰ, ਇਹ ਅਧਿਐਨ ਨਵਜੰਮੇ ਜੀਬੀਐਸ ਬਿਮਾਰੀ ਦੇ ਜੋਖਮ ਦੇ ਸੰਬੰਧ ਵਿੱਚ ਪ੍ਰੀਨੇਟਲ ਐਂਟੀਬਾਇਓਟਿਕ ਐਕਸਪੋਜ਼ਰ ਦੀ ਜਾਂਚ ਕਰਨ ਵਾਲਾ ਪਹਿਲਾ ਅਧਿਐਨ ਹੈ। ਹਾਲਾਂਕਿ, ਇਹ ਪਿਛਲੇ ਨੋਰਡਿਕ ਅਧਿਐਨਾਂ ਨਾਲ ਮੇਲ ਖਾਂਦਾ ਹੈ, ਜਿਸ ਵਿੱਚ ਪ੍ਰੀਨੇਟਲ ਐਂਟੀਬਾਇਓਟਿਕ ਐਕਸਪੋਜ਼ਰ ਤੋਂ ਬਾਅਦ ਸ਼ੁਰੂਆਤੀ ਬਚਪਨ (1-5 ਸਾਲ ਦੀ ਉਮਰ) ਦੌਰਾਨ ਲਾਗਾਂ ਦੇ 16-34 ਪ੍ਰਤੀਸ਼ਤ ਵਧੇ ਹੋਏ ਜੋਖਮ ਦੀ ਰਿਪੋਰਟ ਕੀਤੀ ਗਈ ਸੀ।
ਅਧਿਐਨ ਵਿੱਚ ਪਾਇਆ ਗਿਆ ਕਿ ਡਿਲੀਵਰੀ ਦੇ ਨੇੜੇ (ਚਾਰ ਹਫ਼ਤਿਆਂ ਦੇ ਅੰਦਰ) ਦਿੱਤੇ ਗਏ ਜੀਬੀਐਸ-ਕਿਰਿਆਸ਼ੀਲ ਐਂਟੀਬਾਇਓਟਿਕਸ ਨੇ ਕੋਈ ਸੁਰੱਖਿਆ ਪ੍ਰਦਾਨ ਨਹੀਂ ਕੀਤੀ। ਕਿਸੇ ਵੀ ਐਂਟੀਬਾਇਓਟਿਕਸ ਦੇ ਨਵਜੰਮੇ ਜੀਬੀਐਸ ਬਿਮਾਰੀ ਨਾਲ ਜਨਮ ਤੋਂ ਪਹਿਲਾਂ ਦੇ ਸੰਪਰਕ ਦਾ ਸਬੰਧ ਕਲੀਨਿਕਲ ਜੀਬੀਐਸ ਜੋਖਮ ਕਾਰਕਾਂ ਦੀ ਮੌਜੂਦਗੀ ‘ਤੇ ਨਿਰਭਰ ਕਰਦਾ ਜਾਪਦਾ ਹੈ, ਇੱਕ ਸਕਾਰਾਤਮਕ ਸਬੰਧ ਸਿਰਫ ਅਜਿਹੇ ਜੋਖਮ ਕਾਰਕਾਂ ਤੋਂ ਬਿਨਾਂ ਗਰਭ ਅਵਸਥਾਵਾਂ ਵਿੱਚ ਦੇਖਿਆ ਗਿਆ ਹੈ।
ਹੋਰ ਖਬਰਾਂ ਪੜ੍ਹਨ ਲਈ ਦਿੱਤੇ ਗਏ ਲਿੰਕ ਤੇ ਕਲਿੱਕ ਕਰੋ : https://wishavwarta.in/